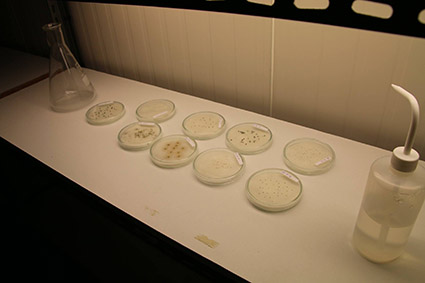
Test de germination

Banque de semences
La conservation ex situ est réalisée sous deux formes au CBN des Hauts-de-France : le stockage de graines en banque de semences et la culture en jardin conservatoire.
La banque de semences contient actuellement 588 taxons (espèces et sous espèces), 1 988 lots, 44 millions de semences. Elle contient également 620 000 graines de 26 taxons provenant d’autres régions françaises ou d’autres pays.
La banque de semences est un outil de sauvegarde à long terme d’un patrimoine génétique de plus en plus menacé de disparition. Certaines populations ayant déjà disparu, le CBN des Hauts-de-France est parfois amené à sortir un lot de la banque de semences pour le mettre en culture et obtenir des plantes qu’on peut réintroduire dans la nature. Cela doit cependant rester une ultime solution. Éviter la disparition des espèces en les préservant dans leur milieu naturel doit rester une priorité.

Procédure technique de mise en conservation :
Les récoltes de semences d’espèces menacées sont réalisées par les botanistes du CBN des Hauts-de-France et parfois par des partenaires. Les lots sont séchés à l’air libre et sont nettoyés à l’aide de tamis ou colonne d’air. Le nettoyage consiste à enlever les petits branchages, résidus de pétales, de capsules, etc. Les lots sont pesés, le nombre de graines est compté ou estimé. Vient alors l’étape importante de la dessiccation. Elle se déroule dans des boîtes hermétiques dans lesquelles sont placés des granulés de silicagel capable d’absorber l’humidité des semences. Cette étape est nécessaire pour placer les semences en conservation au froid dans la banque de semences. Lorsque la dessiccation des semences est suffisante, elles sont placées en sachets étanches protégeant de la lumière et de l’humidité puis mises au froid à 5°C ou -20°C dans des réfrigérateurs ou congélateurs professionnels.
Parallèlement, un test de germination est effectué afin de connaître la capacité à germer des semences. Cette étape est faite dans des boîtes de Pétri dans une chambre de culture où la température et la lumière sont régulées.